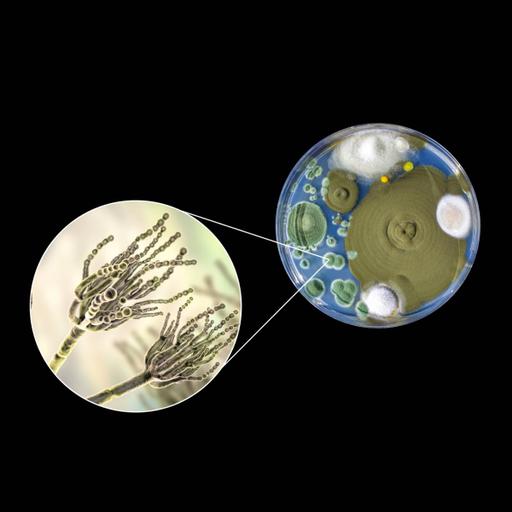
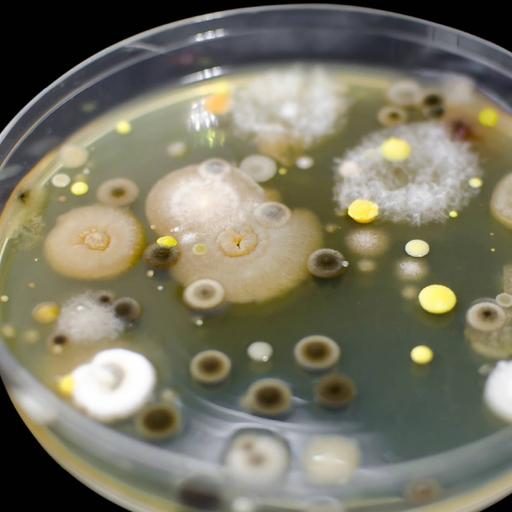

Microbiology
The study of germs or microbes is known as microbiology. Bacteria, algae, fungus, protozoa, and viruses are among the wide group of generally minute basic life-forms. The structure, function, and classification of such creatures, as well as methods of exploiting and managing their activity, are all topics covered in this field. Microorganisms and their activities are critical to almost every process on Earth. Microorganisms are important because they have an impact on every part of our existence. The study of all living organisms that are too small to be seen with the naked eye is known as microbiology. Microbes are bacteria, archaea, viruses, fungus, prions, protozoa, and algae, which are all classified as bacteria. These bacteria are important in nutrient cycling, biodegradation/bio deterioration, climate change, food spoilage, disease origin and control, and many other processes.